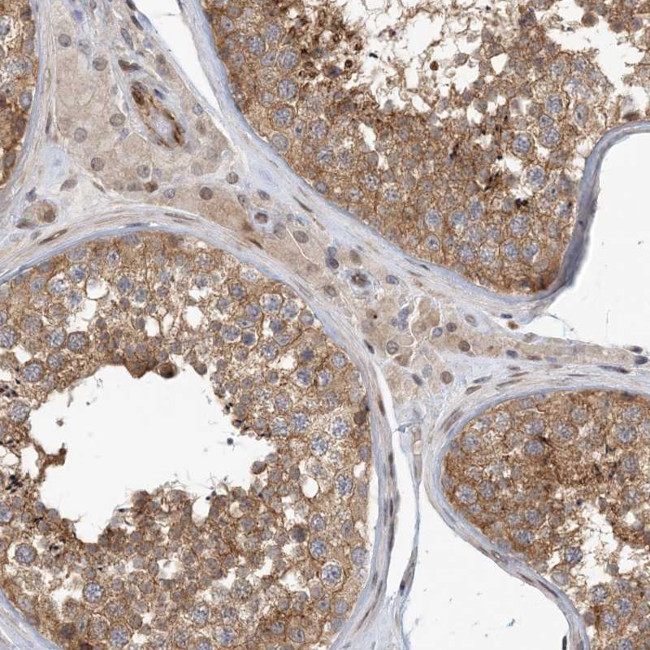
MAPKBP1 Antibody in Immunohistochemistry (Paraffin) (IHC (P))

Search
Invitrogen
MAPKBP1 Polyclonal Antibody
{{$productOrderCtrl.translations['antibody.pdp.commerceCard.promotion.promotions']}}
{{$productOrderCtrl.translations['antibody.pdp.commerceCard.promotion.viewpromo']}}
{{$productOrderCtrl.translations['antibody.pdp.commerceCard.promotion.promocode']}}: {{promo.promoCode}} {{promo.promoTitle}} {{promo.promoDescription}}. {{$productOrderCtrl.translations['antibody.pdp.commerceCard.promotion.learnmore']}}
产品信息
PA5-56570
种属反应
宿主/亚型
分类
类型
抗原
偶联物
形式
浓度
规格
纯化类型
保存液
内含物
保存条件
运输条件
RRID
产品详细信息
Immunogen sequence: EKHSPDSACS VDYSSSCLSS PEHPTEDSES TEPLSVDGIS SDLEEPAEGD EEEEEEEGGM GPYGLQEGSP QTPDQEQFLK QHFETLA
Highest antigen sequence identity to the following orthologs: Mouse - 90%, Rat - 90%.
靶标信息
MAP kinases play a significant role in many biological processes, including cell adhesion and spreading, cell differentiation and apoptosis. MAPKBP-1 (mitogen-activated protein kinase binding protein 1), also known as JNKBP-1, is a 1,514 amino acid protein that contains twelve WD repeats. Induced by TRAF2 (TNF receptor-associated factor 2) and Tak1 (TGF-beta-activated kinase 1), MAPKBP-1 is thought to act an adaptor protein for NFkappaB (nuclear factor kappa-B) activation. MAPKBP-1 interacts with JNK3 and may promote TRAF2 polyubiquitination. MAPKBP-1 exists as six alternatively spliced variants and is encoded by a gene located on human chromosome 15. Human chromosome 15 houses over 700 genes and comprises nearly 3% of the human genome. Angelman syndrome, Prader-Willi syndrome, Tay-Sachs disease and Marfan syndrome are all associated with defects in chromosome 15-localized genes.
仅用于科研。不用于诊断过程。未经明确授权不得转售。
篇参考文献 (0)
生物信息学
蛋白别名: JNK-binding protein 1; JNKBP-1; Mitogen-activated protein kinase-binding protein 1; unnamed protein product
基因别名: JNKBP-1; JNKBP1; KIAA0596; MAPKBP1; NPHP20
UniProt ID: (Human) O60336
Entrez Gene ID: (Human) 23005